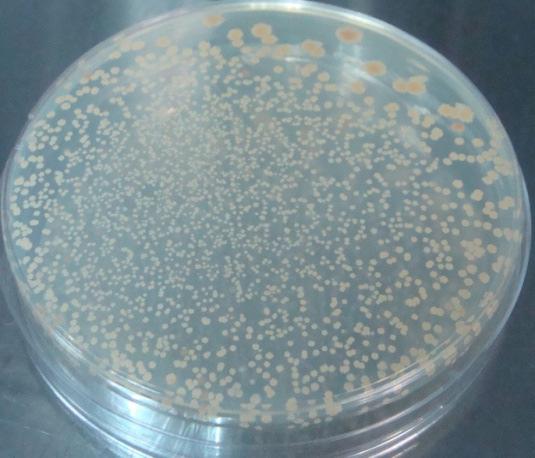
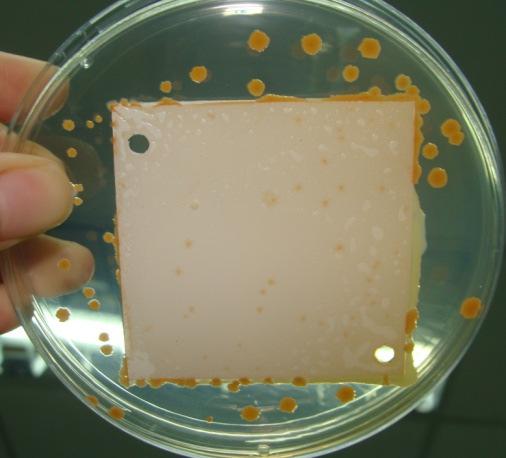
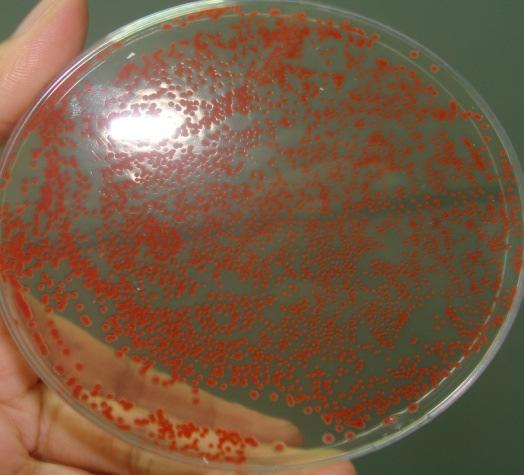
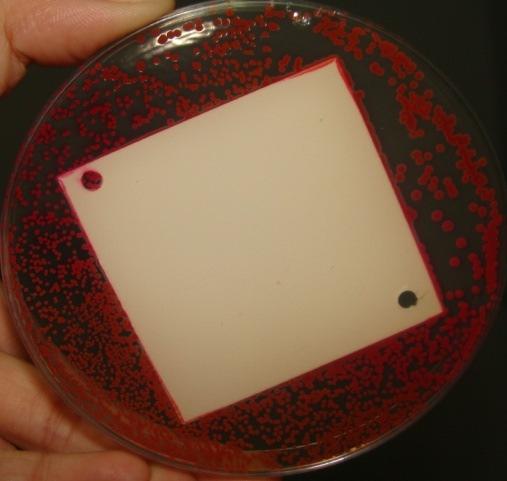
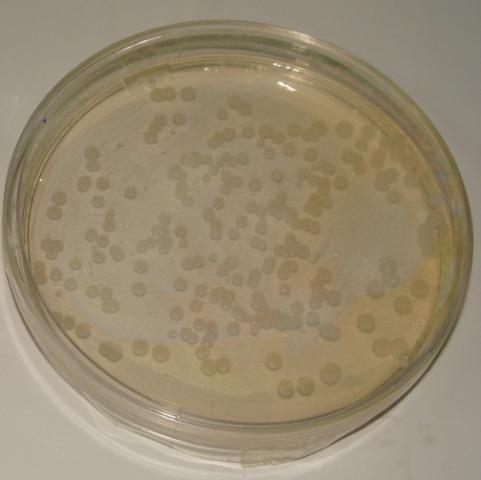
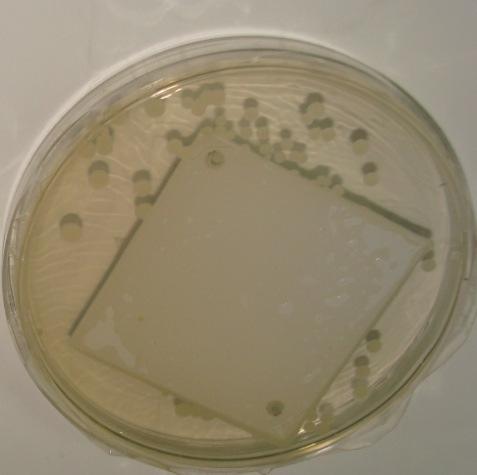
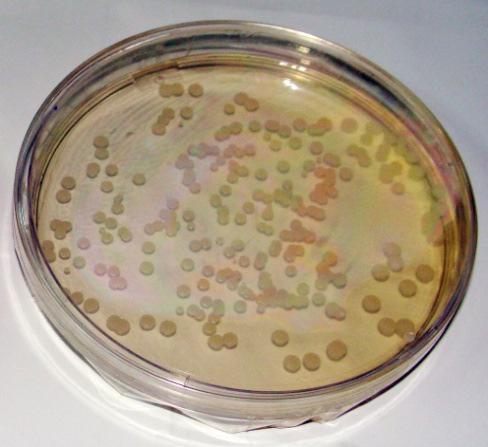
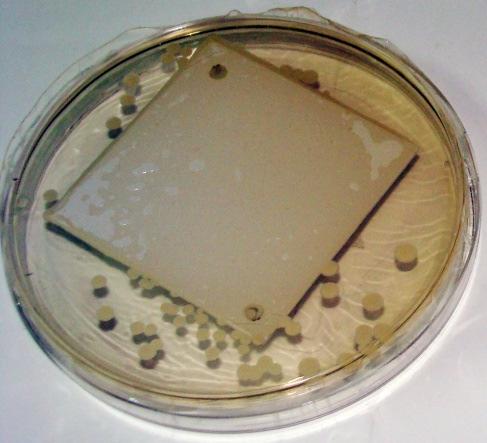
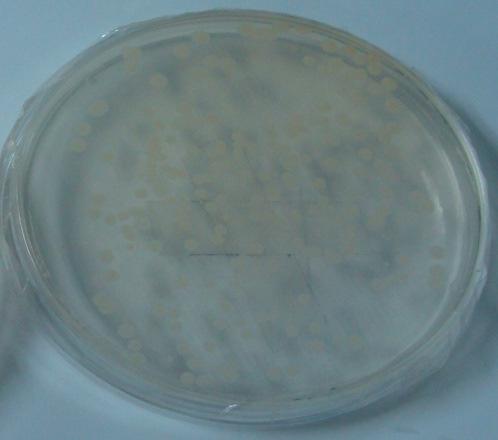
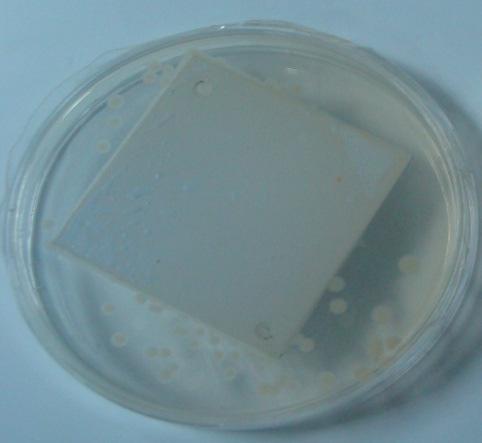
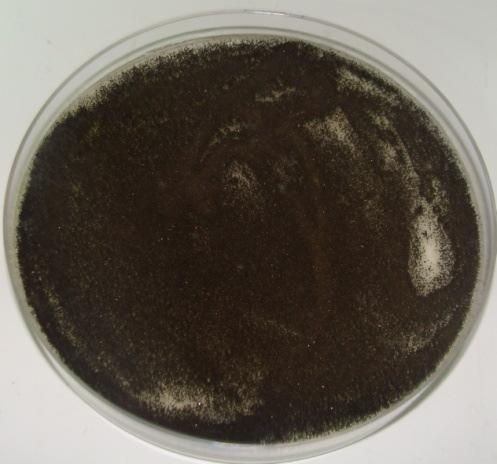

TOPICS
特集記事
ESCO キャビネット製品におけるICOSIDEパウダーコーティングの効果
Abstract:要旨
装置や材料上に存在する微生物はラボの研究者が使用する機器や施設の汚染の原因となりますが、これらを全て清潔な状態に保ち、健康へのリスクを無くすことが重要です。微生物は、一般的に多くの物の表面に存在しますが、その数を効果的に制御することは困難です。
ESCO社は、微生物の増殖を抑制するISOCIDEパウダーコートを施した研究用、クリーンルーム用製品を提供しています。
ESCO社では、ISOCIDEパウダーコーティングの微生物に対する効果を検証するため、JISおよびASTM基準で二種類の試験を実施しました。この試験において、ICOSDEパウダーコーティングされた表面では、バクテリア、酵母、カビが抑制、消失することが示されました。
Introduction:序論
ESCO社は30年以上にわたり、バイオロジカルセフティキャビネット、ラミナーフロークリーンベンチ、動物実験用ワークステーション、オーブン、インキュベーター、実験室用ヒュームフード、PCR、IVFワークステーションなどの環境制御、実験室/クリーンルーム用機器を製造しています。これらの製品は多くの研究室や施設で使用されており、細菌や微生物に曝露されています。
上記の施設内の物品に触れることで、バクテリアやウイルス、菌類、またその他の好ましくない生物により疾患が引き起こされる懸念があります。そのため、研究用機器の表面の生物学的な汚染を防ぐことが重要であり、微生物の増殖を抑制したり、微生物を不活化させる効果(ここでは「抗菌活性」と言います)を有する実験器具・機械を製造するための努力が行われてきました。
Biocidal Products Directive 98/8/EC (BPD)や、米国環境保護庁(EPA)にも、抗菌塗料の有効性を決定するための基準はありませんでしたが、多くの業界団体(ASTM、ISO、JISなど)においては、それぞれが独自に、無孔質上の抗菌製剤活性を決定するための方法を示しています。以下において実施した2つの試験は、JISおよびASTMの試験規格をベースにして開発したものであり、ISOCIDEの抗微生物活性を定性的、定量的に示しています。
Materials and methods:方法
微生物の調整:
本試験に使用したバクテリアは、Bacillus subtilis var globigii、Serratia marcescens、Streptcoccus epidermidis、Enteroccus faecalis、Escherichia coliおよびStaphylococcus aereusです。酵母として、Saccharomyces cerevisiae、Candida albicans、およびRhodotularubraを使用しました。バクテリアおよび酵母は、2回の活性化フェーズを経た後、バクテリアは24時間、酵母は36時間増殖させ、PH7.3のリン酸緩衝液中で調整しました。また、この実験では、Bacillus subtilis var globigiiおよびAspergillus nigerの胞子懸濁液(濃度はそれぞれ1.5×1010、5.0×108個/mL)を使用しました。
試験手順:
A. Qualitative Method: Isocide surface contact testing 定性試験:ISOCIDE表面接触テスト
- 50mm×50mmの電気亜鉛メッキ鋼板をテストプレートとして用意し、防錆のため亜鉛で研磨した後、ISOCIDEパウダーコーティングを吹き付け、180℃のオーブンで焼き付けました。これらのテストプレートは、目に見える汚れを70%イソプロパノールで拭き取った後、試験に備えて20℃の暗所に保管しました。
- 試験用の微生物をそれぞれ寒天培地上に0.1mLずつ滴下し、全体に塗り広げた後、寒天培地の中央にテストプレートを設置しました。使用した寒天培地はそれぞれ、バクテリアはトリプチケースソイ寒天培地、酵母はサボラウドデキストロース寒天培地、カビ類はポテトデキストロース寒天培地です。
- 試験微生物の増殖について、バクテリアは24~48時間、酵母は48~72時間、カビは1週間までの期間観察を行い、培地表面とテストプレートの接面における増殖を記録しました。
B. Quantitative Method: Determination of ISOCIDE log reduction of bioburden 定量試験:微生物の対数減少数
- 20mm×50mmの電気亜鉛メッキ鋼板をテストプレートとして用意し、防錆のため亜鉛で研磨した後、ISOCIDEパウダーコーティングを吹き付け、180℃のオーブンで焼き付けました。これらのテストプレートは、目に見える汚れを70%イソプロパノールで拭き取った後、試験に備えて20℃の暗所に保管しました。
- 接触期間中にテストプレートを保持するためステンレスパンを用意しました。このステンレスパンには、テストプレート背面の汚染物質を除去するため、除染シートを付けました。
- ステンレスパンに敷いた除染シートの上にテストプレートを配置し、試験用微生物を0.1mLずつ滴下し、不要な物質や汚染物質が付着しないよう、ラップで保護しましました。これらのプレートは、湿度管理を行わない状態で、25℃のインキュベーターに設置しました。
- テストプレートを接触時間24時間と48時間でサンプリングし、段階希釈法により微生物の残存CFUを定量し、初期濃度とテストプレートの残存CFUを比較することで対数減少値を得ました。
Result:結果
A. Qualitative Method: Isocide surface contact testing

詳細な結果は以下の通りです。
| Microorganism | Agar Control | Agar with plate |
|---|---|---|
| Bacillus subtilis var globigii | |
|
| Serratia marcescens | |
|
| Staphylococcus aureus | |
|
| Enterococcus faecalis | |
|
| Escherichia coli | |
|
| Aspergillus niger | |
 |
B. Quantitative Method:


Observation:考察
- 定性試験および定量試験により、本試験で使用した全ての微生物は、ISOCIDEパウダーコーティングに接触後24~48時間で増殖が抑制されたか、または完全に不活化されました。
- ISOCIDEの効果は微生物の種類によって異なりました。ISOCIDEの効果が最大限発揮されたのは、Serratia marcescens(24時間後対数減少値5.38, コロニー形成なし)およびEnterococcus faecalis(24時間後対数減少値5.20)でした。
- Bacillus subtilisにおいては対数減少に限界が見られましたが、ISOCIDEに接していたコロニーのサイズは接していない部分のコロニーよりもサイズが小さいままでした。これは、ISOCIDEによって少なくともコロニーの成長が抑制されたことを示唆しています。
Conclusion:結論
ESCO社のISOCIDEパウダーコーティング表面においては、24-48時間後に微生物が死滅するか、またはその増殖を抑制することが認められました。
ISOCIDEの効果は、微生物の種類により異なっていました。汚染されたエリアへアクセスする前には、ホルマリンや二酸化塩素、過酸化水素を使用して除染を行う必要はあるものの、ISOCIDEパウダーコーティングはその表面上の微生物を減少させることによりラボや研究者の安全、キャビネット内のサンプル保護を向上することができます。
Reference:参考文献
- Barret, L., Emerentiana, S., Darrel, S. 2007. Antimicrobial Coating.
- Tesh, F.M. The Regulation of Antimicrobials in Paints and Surface Treatments. Paint and Coating Industry 2004, 7
- Sadasivan, L. 2007. Antimicrobial Coating
資料提供:ESCO社, Antimicrobial Effectiveness of Isocide Powder Coating on Esco BiologicalSafety Cabinets. (PDF)
翻訳・文責:ワケンビーテック株式会社 企画推進部 企画グループ

